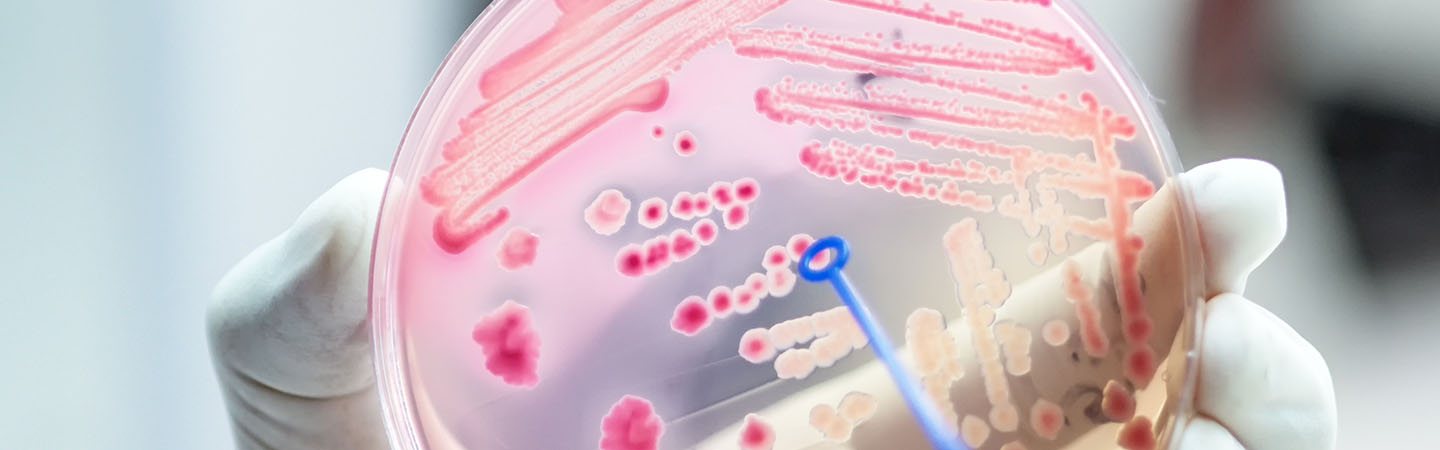

Blutvergiftung: Warum eine Sepsis so gefährlich ist
In Deutschland erkranken ca. 300.000 Menschen im Jahr an einer Blutvergiftung (medizinisch: Sepsis). Bei rund einem Viertel der Patientinnen und Patienten verläuft die Sepsis tödlich. Sie ist damit die dritthäufigste Todesursache. Aber wie bekommt man eine Blutvergiftung und was macht sie so gefährlich?
Eine Blutvergiftung beginnt immer mit einer Infektion. Das kann beispielsweise ein Kratzer oder Insektenstich sein, aber auch eine Lungenentzündung oder ein Harnwegsinfekt. Bei einer Sepsis gerät das gut funktionierende Immunsystem außer Kontrolle: Da die Infektionserreger sich über die Blutbahn verteilen, werden alle Abwehrsysteme aktiviert, wo sonst die Erreger nur direkt rund um die Entzündung bekämpft werden. In der Folge greift unser Immunsystem auch gesunde Zellen und Organe an. Wie schnell sich eine Blutvergiftung entwickelt, hängt dabei sehr von den Erregern und der Konstitution der Betroffenen ab. Es kann schnell gefährlich werden.
Dass man eine Blutvergiftung an einem roten Strich von einer Wunde zum Herzen erkennen kann, ist ein weit verbreiteter Mythos. Die Symptome, die auf eine Sepsis hindeuten, können sehr unterschiedlich sein. Zumal sie auch auf andere – oft näherliegende – Erkrankungen zutreffen. Wachsam sollten Sie werden bei:
- Fieber über 38 Grad Celsius
- Ausgeprägtes Schwächegefühl
- Schüttelfrost
- Niedriger Blutdruck, erhöhter Puls
- Schwere Atmung, Atemnot
- Übelkeit, Erbrechen
Um den Infektionserreger herauszufinden und mit dem passenden Antibiotikum zu therapieren, wird zunächst Blut abgenommen. Da es nicht immer ganz leicht und schnell geht, die Erreger zu bestimmen, wird meist direkt mit einem Breitbandantibiotikum behandelt, um keine Zeit zu verlieren. Denn je später die richtige Therapie beginnt, desto höher das Risiko, dass Organe geschädigt werden oder Gliedmaßen absterben. Eine fortgeschrittene Sepsis ist ein Notfall und die Behandlung erfolgt auf der Intensivstation mit kreislaufstabilisierenden und körperfunktionserhaltenden Maßnahmen.
Mehr dazu:
Da im Grunde fast alle Infektionen eine Sepsis auslösen können, gibt es kein Patentrezept zur Vorbeugung. Aber mit ein paar einfachen Dingen im Alltag lässt sich das Risiko reduzieren:
- Hände und Lebensmittel waschen
- Offene Wunden gründlich mit Wasser säubern und mit Wundspray und Pflaster/Verband versorgen
- Bei Insektenstichen nicht kratzen, damit keine Bakterien eindringen können
- Impfungen z. B. gegen Grippe oder Pneumokokken
- Infektionskrankheiten vom Arzt oder der Ärztin abchecken lassen
- Antibiotika wie verschrieben einnehmen
- Immunsystem stärken – je besser unsere Immunabwehr mit Eindringlingen klarkommt, desto schwerer haben es Erreger uns zu schädigen.
Tetanus (Wundstarrkrampf) wird häufig mit einer Blutvergiftung in Verbindung gebracht. Beides wird durch Bakterien ausgelöst. Doch die Tetanus-Impfung schützt nur vor den Tetanus-Bakterien und leider nicht vor anderen Bakterien, die eine Blutvergiftung verursachen können.
@adobestock_analysis121980